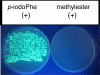
FIGURE 4.

A critical examination of Escherichia coli esterase activity
- PMID: 19666472
- PMCID: PMC2781425
- DOI: 10.1074/jbc.M109.027409
A critical examination of Escherichia coli esterase activity
Abstract
The ability of Escherichia coli to grow on a series of acetylated and glycosylated compounds has been investigated. It is surmised that E. coli maintains low levels of nonspecific esterase activity. This observation may have ramifications for previous reports that relied on nonspecific esterases from E. coli to genetically encode nonnatural amino acids. It had been reported that nonspecific esterases from E. coli deacetylate tri-acetyl O-linked glycosylated serine and threonine in vivo. The glycosylated amino acids were reported to have been genetically encoded into proteins in response to the amber stop codon. However, it is our contention that such amino acids are not utilized in this manner within E. coli. The current results report in vitro analysis of the original enzyme and an in vivo analysis of a glycosylated amino acid. It is concluded that the amber suppression method with nonnatural amino acids may require a caveat for use in certain instances.
Figures

References
-
- Zhang Z., Gildersleeve J., Yang Y. Y., Xu R., Loo J. A., Uryu S., Wong C. H., Schultz P. G. (2004) Science 303, 371–373 - PubMed
-
- Xu R., Hanson S. R., Zhang Z., Yang Y. Y., Schultz P. G., Wong C. H. (2004) J. Am. Chem. Soc. 126, 15654–15655 - PubMed
-
- Xie J., Schultz P. G. (2006) Nat. Rev. Mol. Cell Biol. 7, 775–782 - PubMed
-
- Boos W. (1974) Annu. Rev. Biochem. 43, 123–146 - PubMed
-
- Wells H. G., Corper H. J. (1912) J. Infect. Dis. 11, 388–396
Publication types
MeSH terms
Substances
LinkOut - more resources
Full Text Sources
Other Literature Sources

